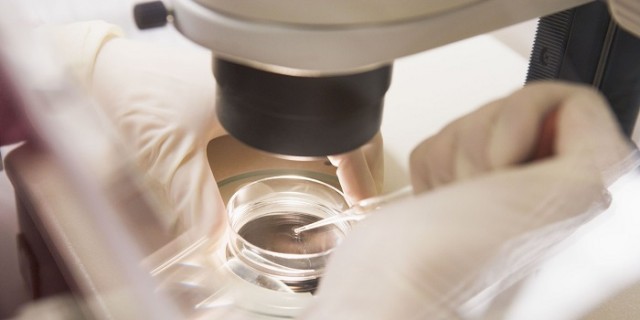
「これはスゴイ!」男性が“無精子症”でも妊娠可能と発表され、喜びが広がる

Sci & Tech Readings

ソフトバンク、「ギガ学割」の特典を毎月3Gから6Gへ拡大へ--KDDIに対抗
ソフトバンクは1月12日、1月15日から実施する「ギガ学割」の特典を変更し、25歳以下のユーザーを対象にしたデータ増量特典を毎月3Gバイトから6Gバイトに拡大したと発表した。ギガ学割は、新規契約(25歳以下のユーザーは機種変更を含む)を対象にしたキャンペーンだ。
梶田さんに埼玉県民栄誉章贈呈 - ノーベル賞受け
埼玉県は12日、素粒子ニュートリノの研究でノーベル物理学賞を受賞した東大宇宙線研究所長の梶田隆章さん(56)に、県民栄誉章を贈呈した。県によると、県出身者のノーベル賞受賞は初めて。 さいたま市の知事公館で行われた贈呈式で、梶田さんは「埼玉県で人生の8割を ...マイナビニュース ·
インフルエンザ、まだ流行期入りせず
国立感染症研究所(感染研)は12日、全国約5千カ所の定点医療機関から報告された年末年始(昨年12月28日~1月3日)のインフルエンザの患者数は1カ所あたり0・89人だったと発表した。流行開始の目安となる1人を下回った。12月までに流行期入りしなかったの ...朝日新聞 ·
iOS 9.3の新機能が判明!ブルーライト軽減やマルチユーザー対応が目玉
みなさん、こんにちは。ASCII(週刊アスキー+ASCII.jp)編集部の吉田ヒロでございます。さて、Appleが開発者向けにiOS 9.3のベータ版を配布しました。通常、配布された事実以外の情報はNDA(Non-Disclosure Agreement、秘密保持契約)の範囲内なのでメディアで取り扱う ...ASCII.jp ·
夏までに平常状態に=エルニーニョ現象—気象庁
気象庁は12日、太平洋赤道域東部の海面水温が平年を上回るエルニーニョ現象が昨年11〜12月にピークを迎え、今後は弱まって今年の春(3〜5月)から夏(6〜8月)の間に平常状態に戻る可能性が高いと発表した。 日本では昨年12月、同現象の影響で全国的に暖かく、 ...
「iOS 9.3」ベータ版公開、日没後のブルーライト軽減やメモのパスワード/Touch IDロック機能など
米Appleは11日、「iOS 9.3」のベータ版を公開した。画面の色温度を変えてブルーライトを軽減させる機能「Night Shift」やメモをパスワード/Touch IDでロックする機能などが追加された。 Night Shiftでは、iOS端末の時間・位置情報から日没時間を割り出し、自動的にディスプレイ ...
au、25歳まで毎月5Gバイト増になるキャンペーン--1Gバイトプランは「間もなく」
KDDI、沖縄セルラーは1月12日、25歳以下で「データ定額5/8/10/13」に契約したユーザー向けに25歳までデータ容量(5Gバイト)を毎月プレゼントするキャンペーンを1月14日より開始すると発表した。期間は5月31日まで。 キャンペーン適用価格. 家族も1年間毎月1000円引きに.
梶田さんに埼玉県民栄誉章贈呈 ノーベル賞受け
埼玉県は12日、素粒子ニュートリノの研究でノーベル物理学賞を受賞した東大宇宙線研究所長の梶田隆章さん(56)に、県民栄誉章を贈呈した。県によると、県出身者のノーベル賞受賞は初めて。 さいたま市の知事公館で行われた贈呈式で、梶田さんは「埼玉県で人生の8割を ...北海道新聞 ·
「これはスゴイ!」男性が“無精子症”でも妊娠可能と発表され、喜びが広がる
北九州市にある不妊治療の専門クリニック「セントマザー産婦人科医院」が、「非閉そく性無精子症」でも精子のもととなる細胞を採取して人工授精できる仕組みを米科学誌PNASに発表した。 同医院では2011年9月~2014年12月までに、前期精子細胞を使った体外受精で112人 ...
帝京平成大、パニック症や恐怖症に共通する遺伝子を発見
帝京平成大学はこのほど、不安症に共通する疾患感受性遺伝子2カ所を発見したと発表した。 同成果は同大の音羽健司 教授と米国バージニア・コモンウェルス大学のジョン・ヘッテマ 准教授らの国際共同研究グループによるもの。1月12日(現地時間)の米科学誌「Molecular ...マイナビニュース ·
高浜原発再稼働へ訓練…重大事故想定 2016年01月12日
関西電力は11日、高浜原子力発電所3、4号機(福井県高浜町)の再稼働に向け、重大事故を想定した訓練を始めた。訓練は3日間で、原子力規制委員会が対応状況を確認する。問題がなければ、関電は28日にも3号機の原子炉を起動。4号機は2月下旬にも再稼働させる方針 ...読売新聞 ·
「Apple Music」、登録ユーザー数が1000万人超に--Financial Times
Financial Timesによると、「Apple Music」は提供開始から6カ月で、有料登録ユーザー数が1000万人を突破したという。競合する音楽ストリーミングサービス「Spotify」は、1000万人のユーザー数を獲得するまでにおよそ6年を要した。 Googleの「Android」OS向けにベータ版を ...
身元不明保護者の公表 自治体HPで46%どまり 認知症などで同意困難
認知症などで身元不明のまま全国で保護された約三百四十人のうち、昨年末時点で都道府県がホームページ(HP)に情報を公開しているのは46%にとどまることが十一日、共同通信のアンケートで分かった。個人情報の公開で「本人同意が得られない」のが主な理由で、意思 ...東京新聞 ·
無病息災願い、大須で左義長 2016年01月12日
正月飾りや古いお札を燃やす「左義長」が11日、名古屋市中区の大須観音で行われ、家族連れなど大勢の参拝者が炎に向かって今年の無病息災を祈った。 左義長は「大ドンド」とも呼ばれる正月明けの恒例行事。僧侶たちが読経する中、境内には門松やしめ縄などが積み上げ ...読売新聞 ·
鬼っ子「もんじゅ」の命運は?廃炉ビジネスも関心 正念場迎えた原発銀座
鬼っ子「もんじゅ」の命運は?廃炉ビジネスも関心 正念場迎えた原発銀座. (1/4ページ). PR. 最後通告が突きつけられている高速増殖炉原型炉「もんじゅ」=福井県敦賀市. 平成23年3月の福島第1原発事故から5年。昨年は九州電力川内原発1、2号機(鹿児島県薩摩川内市) ...産経ニュース ·